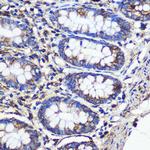
SND1 Antibody in Immunohistochemistry (Paraffin) (IHC (P))

Search
Invitrogen
SND1 Polyclonal Antibody
{{$productOrderCtrl.translations['antibody.pdp.commerceCard.promotion.promotions']}}
{{$productOrderCtrl.translations['antibody.pdp.commerceCard.promotion.viewpromo']}}
{{$productOrderCtrl.translations['antibody.pdp.commerceCard.promotion.promocode']}}: {{promo.promoCode}} {{promo.promoTitle}} {{promo.promoDescription}}. {{$productOrderCtrl.translations['antibody.pdp.commerceCard.promotion.learnmore']}}

Please note: We are reviewing Western blot images included in the antibody testing data in our catalog, including those provided by third parties. Unless expressly labeled or annotated as “raw-unedited”, Western blot images included in the antibody testing data in our catalog may have been edited, optimized or otherwise adjusted for presentation.
产品信息
PA5-96455
种属反应
宿主/亚型
分类
类型
抗原
偶联物
形式
浓度
规格
纯化类型
保存液
内含物
保存条件
运输条件
RRID
产品详细信息
Immunogen sequence: MVLSGCAIIV RGQPRGGPPP ERQINLSNIR AGNLARRAAA TQPDAKDTPD EPWAFPAREF LRKKLIGKEV CFTIENKTPQ GREYGMIYLG KDTNGENIAE SLVAEGLATR REGMRANNPE QNRLSECEEQ AKAAKKGMWS EGNGSHTIRD LKYTIENPRH FVDSHHQKPV NAIIEHVRDG SVVRALLLPD YYLVTVMLSG IKCPTFRREA DGSETPEPFA AEAKFFTESR LLQRDVQIIL ESCHNQNILG TILHPNGNIT; Positive Samples: HeLa, Jurkat, HL-60, MCF7, 293T, Mouse liver, Rat liver; Cellular Location: Cytoplasm, Melanosome, Nucleus
靶标信息
SND1/P100 (staphylococcal nuclease and tudor domain containing 1), also known as TudorSN, functions in the Pim-1 regulation of Myb activity and acts as a transcriptional activator of EBNA-2. It also interacts with EAV, NSP1, GTF2E1 and GTF2E2, and forms a ternary complex with Stat6 and POLR2A. The staphylococcal nuclease-like (SN)-domains directly interact with amino acids 1099-1758 of CBP. SND1/P100 plays an important role in the assembly of Stat6 transcriptome and stimulates IL-4-dependent transcription by mediating interaction between Stat6 and CBP.
仅用于科研。不用于诊断过程。未经明确授权不得转售。
篇参考文献 (0)
生物信息学
蛋白别名: 100 kDa coactivator; p100 co-activator; p105 coactivator; SND p102; staphylococcal nuclease domain containing 1; Staphylococcal nuclease domain-containing protein 1; TudorSN
基因别名: AL033314; SND p102; Snd1; Tudor-SN
UniProt ID: (Rat) Q66X93, (Mouse) Q78PY7
Entrez Gene ID: (Rat) 64635, (Mouse) 56463




